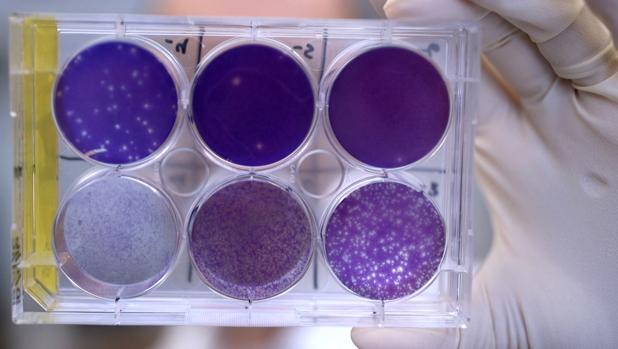
El Diario de San Pedro | Noticias locales y regionales

(NA) – Un grupo de investigadores logró que un anticuerpo recolectado de personas que sobrevivieron al zika protegiera a los fetos de ratonas preñadas, un anuncio hecho este lunes que resucitó las esperanzas de encontrar un tratamiento contra la enfermedad.
En el laboratorio, el anticuerpo neutralizó todas las cepas conocidas de zika y redujo «visiblemente» los niveles del virus en los roedores infectados y en sus fetos.
«Este es el primer antiviral que se ha demostrado que funciona en el embarazo para proteger a fetos en gestación», dijo el académico de la Escuela de Medicina de la Universidad de Washington, Michael Diamond, uno de los coautores del estudio.
«Esto es una prueba del principio de que el virus es tratable durante el embarazo y ya tenemos un anticuerpo humano que lo trata, al menos en un ratón», destacó el científico.
El virus del Zika es considerado por la OMS como una emergencia de salud pública mundial. Se transmite por la picadura del mosquito Aedes aegypti y en menor medida por vía sexual.
Si una mujer embarazada está infectada con zika tiene un mayor riesgo de dar a luz a un niño con malformación de cerebro, conocido como microcefalia.
Según la OMS, desde 2015 en todo el mundo han nacido 2.300 niños con malformaciones como microcefalia y otras patologías relacionadas con el Zika, la mayoría de ellos en Brasil.
Desde entonces, no se ha encontrado una cura o una vacuna que proteja a la población.
Para su trabajo, Diamond y su equipo obtuvieron muestras de anticuerpos de personas que sobrevivieron a la enfermedad.
Los anticuerpos, que son la primera barrera de defensa humana, son proteínas con la forma de una Y, y son efectivos a la presencia de determinados patógenos, conocidos como sus antígenos.
Al detectar un antígeno, los anticuerpos reaccionan como una tropa de soldados rasos que los eliminan o los inmovilizan para que sean suprimidos por otros agentes que forman el contingente del sistema inmune.
En el estudio publicado por la revista Nature, los investigadores destacaron la acción de un anticuerpo bautizado como ZIKV-117.
Esta proteína tan especial sólo fue encontrada en una persona.
Los investigadores le dieron el anticuerpo ZIKV-117 a ratonas preñadas y los resultados de la investigación mostraron que el virus del Zika no logró alterar la placenta.
«Casi todos los fetos quedaron protegidos contra la infección y la enfermedad», explicó Diamond a la AFP.
Pero en la lucha contra el zika, estos resultados son muy preliminares, ya que pese a la efectividad de estos anticuerpos en los ratones, una barrera de este tipo que proteja a un feto humano tiene que ser mucho más robusta.
Entonces, el experimento debe ser conducido en monos, cuyo proceso de embarazo, es similar al de los humanos.